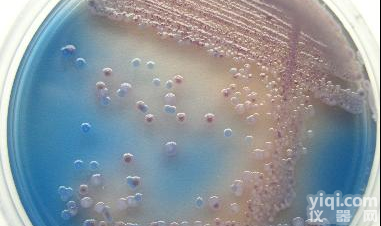
CHROMagar法国<em>科玛嘉ECC显色培养基</em>

科玛嘉ECC显色培养基
- 品牌:科玛嘉
- 型号:1000ml
- 产地:进口
- 供应商:天康信(北京)科技有限公司
- 标签:科玛嘉ECC显色培养基, 货号:, 科玛嘉, 1000ml, 天康信(北京)科技有限公司,科玛嘉ECC显色培养基报价/价格,销售,使用,原理,操作,说明书,资料下载,促销,技术参数,维修,保修,售后服务,代理商,经销商,技术支持,进口/国产,用途
天康信(北京)科技有限公司是国内食品安全检测试剂供应商之一。面对高端用户,为客户提供全面解决方案和专心服务。 我们致力了解和重视客户的需求,以群策群力的态度制定工作计划及完成既定目标。我们认为整体团队的积极参与和合作是成功的重要因素。我们提倡以自强不息的精神建立一支充满自信而勇于承担的工作队伍。我们力求所工作均符合业内的质量标准。联系电话:18501255837,欢迎咨询。
CHROMagar法国科玛嘉显色培养基
品 名 用 途 规 格 单 价
科玛嘉念珠菌显色培养基 用于分离和鉴定主要致病性念珠菌 1000ml
科玛嘉定位显色培养基 用于尿道细菌分离和鉴定,也可用于伤口感染标本的病原菌分离 1000ml
科玛嘉大肠杆菌显色培养基 用于大肠杆菌鉴定和计数 1000ml
科玛嘉ECC显色培养基 用于大肠杆菌和大肠菌群的鉴定和计数 1000ml
科玛嘉O157显色培养基 用于大肠杆菌O157的分离和鉴定 1000ml
科玛嘉O157显色培养基(改进型) 用于大肠杆菌O157的分离和鉴定 1000ml
科玛嘉金黄色葡萄球菌显色培养基 用于金黄色葡萄球菌的鉴定和计数 1000ml 科玛嘉MR
SA显色培养基 用于耐甲氧西林金黄色葡萄球菌的分离和鉴定 1000ml
科玛嘉李斯特菌显色培养基 用于产单核李斯特菌分离和鉴定 1000ml
科玛嘉弧菌显色培养基 用于霍乱弧菌、副溶血弧菌的分离和鉴定 1000ml
科玛嘉沙门氏菌显色培养基 用于鉴定包括伤寒杆菌在内的沙门氏菌 1000ml
科玛嘉沙门氏菌显色培养基(改进型) 用于伤寒杆菌、乳糖阳性沙门氏菌的鉴定 1000ml
科玛嘉VRE显色培养基 用于耐万古霉素肠球菌的分离及鉴定 1000ml
科玛嘉假单胞菌显色培养基 用于假单胞菌的分离和鉴定 1000ml
科玛嘉B群链球菌显色培养基 用于临床标本中分离和检测B群链球菌 1000ml
科玛嘉O104H4肠出血性大肠杆菌显色培养基 用于肠出血性大肠杆菌分离和鉴定 1000ml